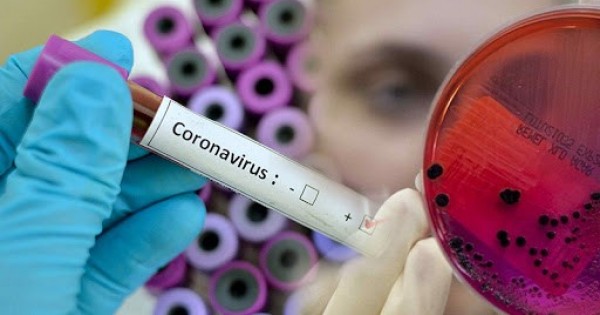

ەلىمىزدە بارلىعى 4 669 ادام COVID-19-دان ەمدەلىپ, ساۋىعىپ شىقتى. نۇر-سۇلتان قالاسى – 974, الماتى قالاسى – 1330, شىمكەنت قالاسى – 230, اقمولا وبلىسى – 106, اقتوبە وبلىسى – 175, الماتى وبلىسى – 180, اتىراۋ وبلىسى – 236, شىعىس قازاقستان وبلىسى – 50, جامبىل وبلىسى – 173, باتىس قازاقستان وبلىسى – 252, قاراعاندى وبلىسى – 193, قوستاناي وبلىسى – 60, قىزىلوردا وبلىسى – 231, ماڭعىستاۋ وبلىسى – 111, پاۆلودار وبلىسى – 148, سولتۇستىك قازاقستان وبلىسى – 33, تۇركىستان وبلىسى – 187.





































